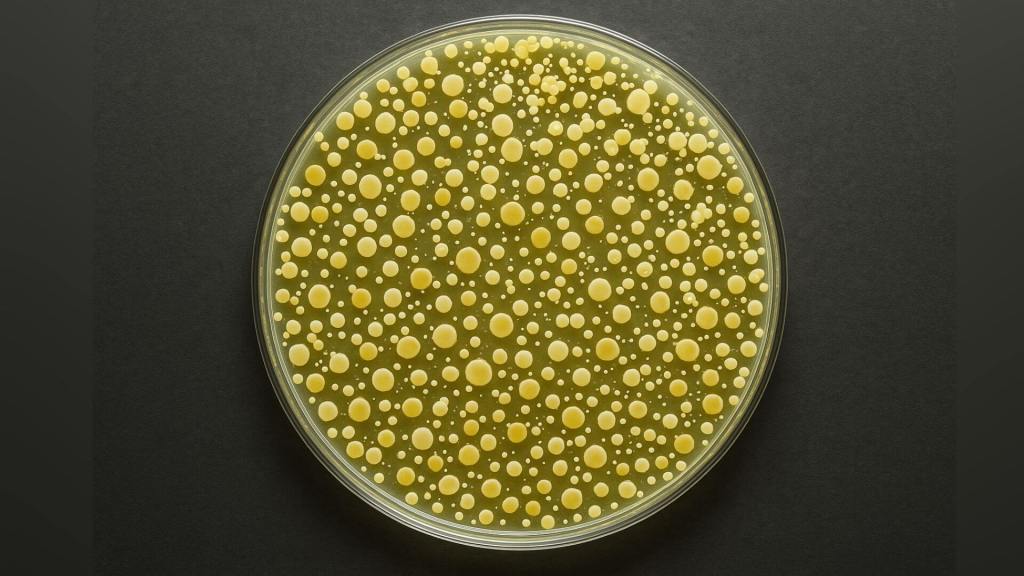

El miedo al colapso ya no es una idea apocalíptica reservada a novelas o películas. Es una sensación extendida, íntima, que muchos experimentan al mirar las noticias, al observar el clima, al intentar prever el futuro. ¿Estamos al borde de un colapso social, ecológico o mental? ¿Cómo podemos encontrar equilibrio en medio del caos? Estas preguntas no solo son pertinentes, sino urgentes, y Andrea Bariselli las aborda con profundidad en uno de los capítulos más intensos de su libro Naturaleza y neurociencia (Pinolia, 2025).
Hoy compartimos contigo ese capítulo completo, para que puedas sumergirte en una reflexión lúcida y provocadora sobre los sistemas complejos, la entropía, y esa frontera difusa donde el desorden y el aprendizaje se dan la mano. Una lectura que no ofrece soluciones mágicas, pero sí claves poderosas para entender el momento que vivimos y la forma en que nuestras mentes —y nuestras sociedades— responden al caos.
La entropía y el espacio de las posibilidades (Andrea Bariselli)
¿Estamos cerca del colapso final? Es inútil darle vueltas. Muchos de nosotros en estos meses, años, estamos experimentando un miedo sin precedentes: que todo pueda colapsar en algún momento. Colapsar. Y las razones para creerlo parecen ser muchas, desde las continuas crisis financieras especulativas hasta las guerras violentas al estilo del siglo xx, pasando por el inminente y apremiante cambio climático. La sensación de que todo se ha vuelto exponencialmente complicado —«complejo», para ser exactos— es real. Y la complejidad está en parte relacionada con el caos: más concretamente, porque, en condiciones adecuadas, un sistema complejo puede evolucionar o tener una transición al caos. Para sobrevivir en entornos que cambian continuamente, es fundamental alcanzar un equilibrio entre un orden demasiado rígido y un desorden excesivo. Este equilibrio se encuentra en una zona llamada «frontera del caos», donde se encuentra el máximo potencial de evolución.
El concepto de frontera del caos me parece extraordinariamente sugerente. ¿Cuál es nuestro límite? ¿Hacia dónde nos estamos precipitando a toda velocidad? Porque tengo la clara sensación de que, al igual que el fuselaje de un transbordador se desintegra al entrar en contacto con la atmósfera durante el regreso a la Tierra, nuestras vidas también sufren la fricción de esta continua exposición al caos. Y lo que se está desintegrando somos nosotros.
Los sistemas colapsan no solo cuando uno de los componentes que los forman falla, sino también cuando desencadena el colapso de los elementos circundantes. Estos, a su vez, conducen a la destrucción de otras partes, lo que provoca un colapso que se propaga rápidamente. Como decía Séneca, «la decadencia es rápida». Es una característica típica de los sistemas que llamamos «redes», de los que nuestro mundo está abundantemente poblado.
Quienes están familiarizados con la biología saben bien lo que sucede a menudo en las placas de Petri, esos recipientes circulares y transparentes donde se cultivan las colonias bacterianas. Una vez inoculados, algunos hongos o bacterias comienzan a reproducirse lentamente, para luego crecer constantemente, aumentando el ritmo. Cada vez más rápido, de manera voraz. Porque encuentran alimento y proliferan hasta el infinito. Como si su comida también fuera infinita. Pero no lo es. Su crecimiento es exponencial, maravillosamente bullicioso y caótico. Hasta que encuentran el «límite». Y ahí todo se detiene y colapsa. Fin.
Observar a estas criaturas es especialmente educativo, porque nos enseña que solo es posible proliferar manteniendo un equilibrio.
Los sistemas complejos y capaces de adaptarse, como las sociedades, tienden a situarse en esta zona. Cerca de la frontera. Ni un paso antes ni un paso después. No son ni completamente ordenados, como un mecanismo fijo, ni completamente caóticos, como la anarquía. En esta zona, llamada «espacio de posibilidades», los sistemas pueden elegir entre diferentes acciones. Aquí muestran su máxima creatividad y complejidad, evolucionando y adaptándose gracias a su capacidad de aprendizaje.

He aquí una posible respuesta al caos: el espacio de las posibilidades. Un limbo donde nuestra sociedad aún puede jugar sus cartas. Y no pocas. Comprender y visualizar en qué espacios podemos seguir contando es el punto de partida para dar los primeros pasos en la dirección correcta.
Esto también nos lo enseña el concepto de «entropía», al que estoy muy vinculado. En términos sencillos, la entropía mide cuán desordenado está un sistema. Cuanto más desordenado está un sistema, mayor es su entropía. No solo se aplica a los átomos y las moléculas, sino que puede ser una metáfora para comprender también los fenómenos sociales y personales. En nuestras vidas, la entropía se manifiesta en la sensación de desorden e imprevisibilidad que a menudo percibimos, especialmente en tiempos turbulentos como los que estamos viviendo. El mundo moderno, con sus rápidas evoluciones tecnológicas, sociales y ambientales, parece moverse constantemente hacia un aumento de la entropía. Tanto es así que hay varias teorías físicas que hablan de una posible «muerte entrópica» del universo: se trata de un concepto relacionado con la segunda ley de la termodinámica, que sugiere el aumento constante e imparable de la entropía, es decir, del desorden, del caos. De hecho, según este principio, la entropía de un sistema aislado (como puede ser el planeta Tierra) nunca disminuye espontáneamente: siempre tiende a aumentar.
Si queremos aplicarlo a todo el universo, el segundo principio de la termodinámica nos sugiere que todo evolucionará gradualmente hacia un estado de máxima entropía, donde cualquier forma de energía se distribuirá de manera uniforme y no habrá gradientes (diferencias de temperatura, por ejemplo) que puedan sostener procesos que aumenten la entropía. En este estado, no habrá más energía utilizable para realizar trabajo, y el universo alcanzará una especie de «muerte térmica» o paradójico «equilibrio térmico». ¿Recuerdan las bacterias que colonizaron toda la placa? No queda nada. En un escenario de muerte entrópica, el universo se convertiría en un lugar homogéneo y uniforme, sin estrellas, planetas u otras formas de estructura compleja. La temperatura estaría muy cerca del cero absoluto. Este es uno de los posibles destinos finales del universo, aunque el proceso para alcanzarlo podría llevar una cantidad de tiempo increíblemente larga, mucho más allá de la edad actual del universo. Gracias al cielo.
Sin embargo, al igual que en el universo, donde la entropía puede verse como una fuerza motriz que favorece el cambio y la evolución, también en nuestros tiempos caóticos en la Tierra este impulso puede ser un catalizador para el crecimiento personal y social. Nos empuja a adaptarnos, a encontrar nuevas soluciones. A evolucionar para no sucumbir al caos que impregna nuestro mundo y, a menudo, también nuestras vidas. De esta manera, la entropía, tanto en el microcosmos de las partículas como en el macrocosmos de las sociedades humanas, se manifiesta no solo como un desafío, sino también como una fuente de potencial renovación.
Me resultaba inevitable, en la parte final de este libro, pensar en el futuro y en las cosas más importantes. En cuáles son las pequeñas luces que debemos mantener encendidas para poder ver dónde apoyar nuestros pasos. En lo que, quizá trabajando en nosotros mismos, deberíamos convertirnos.
Lo que sigue es una especie de colección, una antología de notas y reflexiones que he ido madurando a lo largo de estos años. Son piedras colocadas en mi mente para recordarme lo que puede hacernos mejores, libres, quizá incluso felices.
